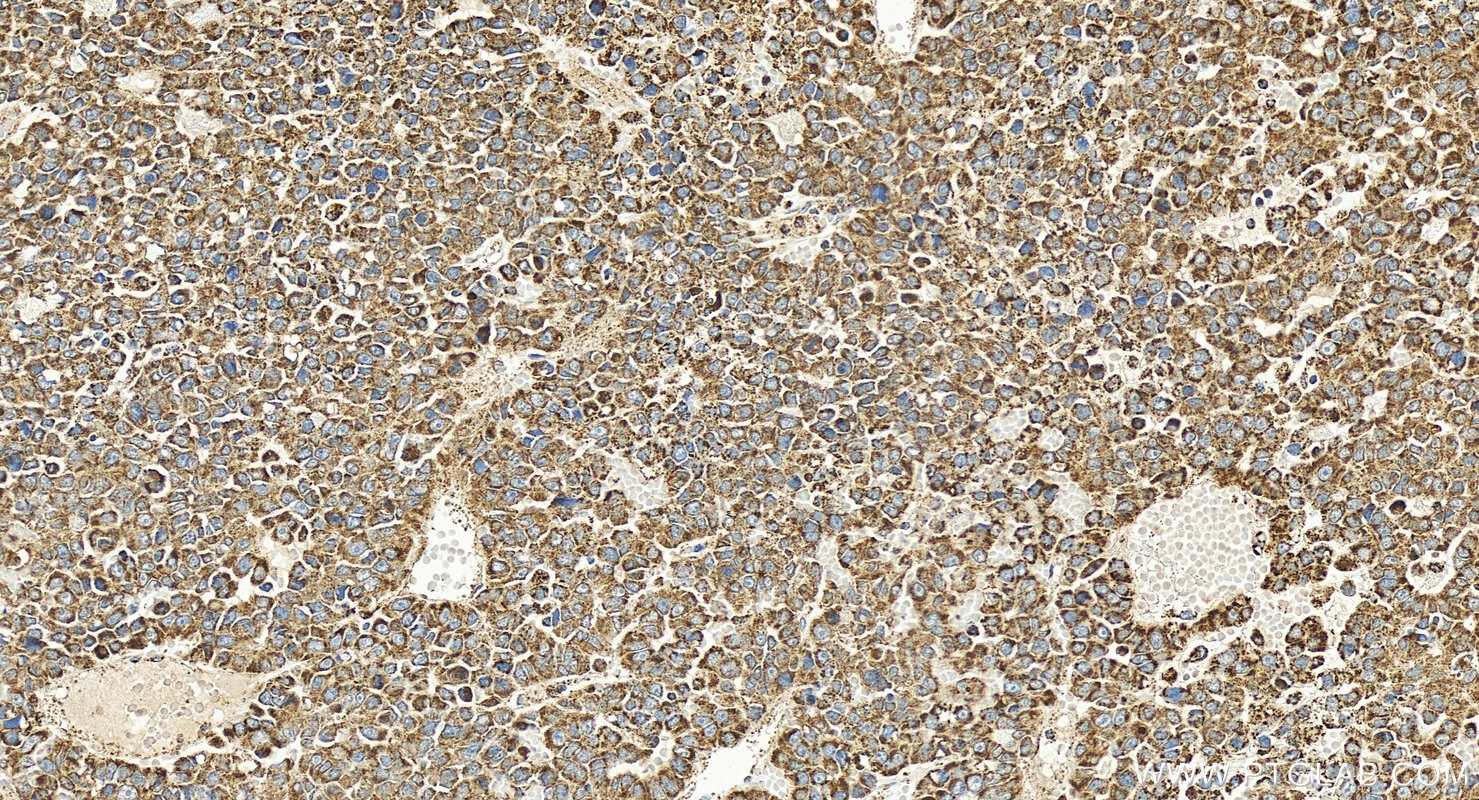
Immunohistochemistry (IHC) staining of human hepatocellular carcinoma using SOD2 Polyclonal antibody (24127-1-AP)

Tested Applications
| Positive WB detected in | DU 145 cells, HEK-293 cells, HeLa cells, mouse brain tissue, rat brain tissue |
| Positive IP detected in | mouse brain tissue |
| Positive IHC detected in | human liver cancer tissue, human breast cancer tissue, human colon tissue, human hepatocellular carcinoma Note: suggested antigen retrieval with TE buffer pH 9.0; (*) Alternatively, antigen retrieval may be performed with citrate buffer pH 6.0 |
| Positive IF/ICC detected in | HUVEC cells, HeLa cells |
Recommended dilution
| Application | Dilution |
|---|---|
| Western Blot (WB) | WB : 1:5000-1:50000 |
| Immunoprecipitation (IP) | IP : 0.5-4.0 ug for 1.0-3.0 mg of total protein lysate |
| Immunohistochemistry (IHC) | IHC : 1:500-1:2000 |
| Immunofluorescence (IF)/ICC | IF/ICC : 1:200-1:800 |
| It is recommended that this reagent should be titrated in each testing system to obtain optimal results. | |
| Sample-dependent, Check data in validation data gallery. | |
Published Applications
| WB | See 363 publications below |
| IHC | See 32 publications below |
| IF | See 42 publications below |
| IP | See 5 publications below |
| ELISA | See 1 publications below |
| CoIP | See 4 publications below |
Product Information
24127-1-AP targets SOD2 in WB, IHC, IF/ICC, IP, CoIP, ELISA applications and shows reactivity with human, mouse, rat samples.
| Tested Reactivity | human, mouse, rat |
| Cited Reactivity | human, mouse, rat, pig, chicken, zebrafish, bovine, sheep, goat |
| Host / Isotype | Rabbit / IgG |
| Class | Polyclonal |
| Type | Antibody |
| Immunogen |
CatNo: Ag21388 Product name: Recombinant human SOD2 protein Source: e coli.-derived, PET28a Tag: 6*His Domain: 1-140 aa of BC016934 Sequence: MLSRAVCGTSRQLAPALGYLGSRQKHSLPDLPYDYGALEPHINAQIMQLHHSKHHAAYVNNLNVTEEKYQEALAKGRFQAERREAVPGRGDPREPGPIRTGLSVEENSLRICTGSEFSRHDSLSFKHMVYLIVEGVPRWV Predict reactive species |
| Full Name | superoxide dismutase 2, mitochondrial |
| Calculated Molecular Weight | 25 kDa |
| Observed Molecular Weight | 25 kDa |
| GenBank Accession Number | BC016934 |
| Gene Symbol | SOD2 |
| Gene ID (NCBI) | 6648 |
| RRID | AB_2879437 |
| Conjugate | Unconjugated |
| Form | Liquid |
| Purification Method | Antigen affinity purification |
| UNIPROT ID | P04179 |
| Storage Buffer | PBS with 0.02% sodium azide and 50% glycerol, pH 7.3. |
| Storage Conditions | Store at -20°C. Stable for one year after shipment. Aliquoting is unnecessary for -20oC storage. 20ul sizes contain 0.1% BSA. |
Background Information
Superoxide dismutase 2 (SOD2), also known as MnSOD (manganese-dependent superoxide dismutase), is a
mitochondrial enzyme that dismutates superoxide ions.
What is the molecular weight of SOD2? Is SOD2 post-translationally modified?
The molecular weight of SOD2 is 25 kDa. SOD2 acts as a homotetramer with manganese ion. SOD2 can be
post-translationally modified, including phosphorylation, nitration, and acetylation. Phosphorylation of SOD2
increases its enzymatic activity and occurs as part of the adaptive response to radiation stress (PMID: 23243068),
while nitration and acetylation decrease SOD2 enzymatic activity (PMID: 20106845, 21172655).
What is the subcellular localization of superoxide dismutases?
SOD2 is the only superoxide dismutase that localizes to the mitochondrial matrix (PMID: 4578091). SOD1 is
predominantly found in the cytoplasm and to a lesser extent in the mitochondrial intermembrane space and
nucleus (PMID: 11507097), while SOD3 localizes extracellularly.
What is the role of SOD2 in neutralizing reactive oxygen species (ROS)?
Superoxide is a main form of ROS that originates directly from the electron transport chain in the mitochondrial
matrix. SOD2 plays a crucial role in mitochondrial ROS homeostasis by catalyzing turnover of superoxide radicals
to hydrogen peroxide and molecular oxygen. ROS are potent physiological signaling molecules but at high doses
they contribute to the pathogenesis of many diseases, including cardiovascular and neurodegenerative diseases
and cancer (PMID: 29669742). SOD2 also associates with mitochondrial DNA (mtDNA), protecting it from
oxidative damage (PMID: 19228881).
What is the tissue expression pattern of SOD2?
SOD2 is ubiquitously expressed.
Can SOD2 be used as a marker of oxidative stress?
SOD2 is a key player in antioxidant defense and contributes to the regulation of oxidative stress. Defects in SOD2
activity or levels can result in oxidative stress. However, SOD2 cannot be used as a marker of oxidative stress
because its expression is not always altered by oxygen stress.
Protocols
| Product Specific Protocols | |
|---|---|
| IF protocol for SOD2 antibody 24127-1-AP | Download protocol |
| IHC protocol for SOD2 antibody 24127-1-AP | Download protocol |
| IP protocol for SOD2 antibody 24127-1-AP | Download protocol |
| WB protocol for SOD2 antibody 24127-1-AP | Download protocol |
| Standard Protocols | |
|---|---|
| Click here to view our Standard Protocols |
Publications
| Species | Application | Title |
|---|---|---|
Bioact Mater End-tail soaking strategy toward robust and biomimetic sandwich-layered hydrogels for full-thickness bone regeneration | ||
ACS Nano Mesenchymal Stem Cell-Derived Extracellular Vesicles Attenuate Mitochondrial Damage and Inflammation by Stabilizing Mitochondrial DNA. | ||
Adv Sci (Weinh) IGFBP1 Sustains Cell Survival during Spatially-Confined Migration and Promotes Tumor Metastasis | ||
Nat Commun Suppression of mitochondrial ROS by prohibitin drives glioblastoma progression and therapeutic resistance. | ||
Redox Biol miR-484 mediates oxidative stress-induced ovarian dysfunction and promotes granulosa cell apoptosis via SESN2 downregulation |
Reviews
The reviews below have been submitted by verified Proteintech customers who received an incentive for providing their feedback.
FH Emilie (Verified Customer) (09-24-2025) | Clear and specific bands were obtained at the expected molecular weight.
|
FH Manon (Verified Customer) (09-22-2025) | Beautiful band slightly below 25 kDa
|
FH Macarena Lucia (Verified Customer) (10-17-2022) | clear band.
|